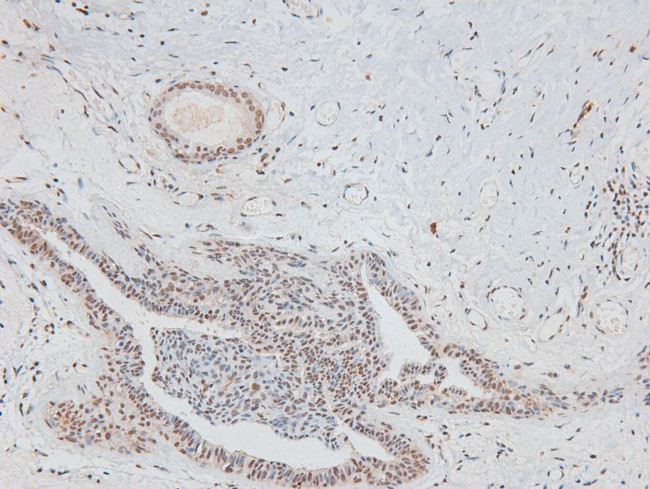
Phospho-CD150 (Tyr327) Antibody in Immunohistochemistry (Paraffin) (IHC (P))

Search
Invitrogen
Phospho-CD150 (Tyr327) Polyclonal Antibody
{{$productOrderCtrl.translations['antibody.pdp.commerceCard.promotion.promotions']}}
{{$productOrderCtrl.translations['antibody.pdp.commerceCard.promotion.viewpromo']}}
{{$productOrderCtrl.translations['antibody.pdp.commerceCard.promotion.promocode']}}: {{promo.promoCode}} {{promo.promoTitle}} {{promo.promoDescription}}. {{$productOrderCtrl.translations['antibody.pdp.commerceCard.promotion.learnmore']}}
图: 1 / 4
Phospho-CD150 (Tyr327) Antibody (PA5-105781) in IHC (P)




Please note: We are reviewing Western blot images included in the antibody testing data in our catalog, including those provided by third parties. Unless expressly labeled or annotated as “raw-unedited”, Western blot images included in the antibody testing data in our catalog may have been edited, optimized or otherwise adjusted for presentation.
产品信息
PA5-105781
种属反应
宿主/亚型
分类
类型
抗原
偶联物
形式
浓度
规格
纯化类型
保存液
内含物
保存条件
运输条件
RRID
产品详细信息
Antibody detects endogenous levels of SLAM / CD150 only when phosphorylated at Tyr327.
靶标信息
CD150, also known as SLAM (Signaling Lymphocyte Activation Molecule), is a member of the immunoglobulin gene superfamily and plays a crucial role in T cell stimulation and immune cell interactions. It is constitutively expressed on peripheral blood memory T cells, T cell clones, immature thymocytes, and a proportion of B cells. CD150 expression is rapidly upregulated upon activation, particularly on naive T cells, Th1 cells, and activated B cells, which express the membrane-bound, soluble, and cytoplasmic isoforms of SLAM. In T cells, signaling through SLAM induces proliferation and enhances the interferon-gamma response. SLAM is also involved in adhesion between T cells and antigen-presenting cells, facilitating immune cell interactions. Homophilic SLAM-SLAM binding during B to B and B to T cell interactions is suggested to enhance the expansion and differentiation of activated B cells. CD150 serves as a receptor for the measles virus and acts as a co-activator on T and B cells. It interacts with SH2D1A and PTPN11 via its cytoplasmic domain, playing a role in signal transduction. Mutations in the CD150 gene may be associated with X-linked lymphoproliferative disease (XLP), highlighting its importance in immune regulation and disease pathology.
仅用于科研。不用于诊断过程。未经明确授权不得转售。
篇参考文献 (0)
生物信息学
蛋白别名: CD150; CD150 antigen; CDw150; IPO-3; signaling lymphocyte activation molecule; Signaling lymphocytic activation molecule; SLAM family member 1
基因别名: 4933415F16; AA177906; CD150; CDw150; ESTM51; IPO-3; RGD1560634; SLAM; SLAMF1
UniProt ID: (Mouse) Q9QUM4
Entrez Gene ID: (Rat) 498286, (Mouse) 27218